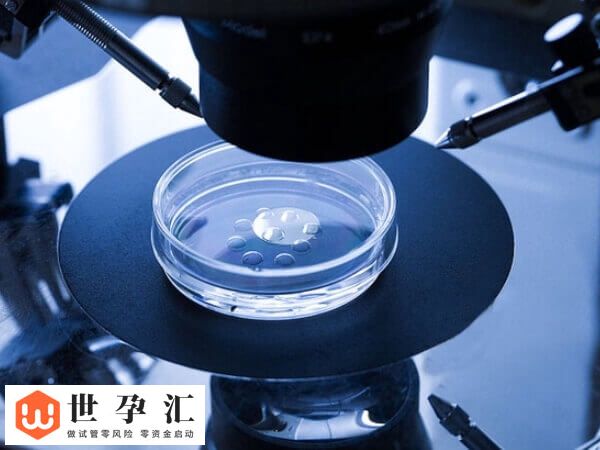
4bc和4ac哪个是最差的囊胚？移植成功率分别是多高呢？(图1)

4bc和4ac哪个是最差的囊胚?移植成功率分别是多高呢?
在囊胚评级中,4bc和4ac均属于可利用囊胚,都不属于最差的囊胚,一般这两种囊胚移植之后,在身体状态较好、内膜环境好的情况下,移植后的成功率是比较高的,大概在40%-50%不等,反之移植成功率可能会降低。不过具体的移植成功率还受母体身体状况、子宫环境等因素影响。
4bc和4ac囊胚质量
在囊胚评级体系中,最差的通常是4cc或6cc等以“cc”结尾的评级。而针对4bc和4ac囊胚质量来说,并不算最差的质量,至于4bc和4ac囊胚质量怎么样,如下所示:
4bc囊胚
4bc囊胚中的“4”代表囊胚处于扩张期(4期),是可移植的合适阶段。“b”表示内细胞团细胞数量较少、排列松散;“c”表示滋养层细胞稀疏。这虽然质量不如4aa、4ab等优质囊胚,但仍属于可利用囊胚,有一定移植成功率。
4ac囊胚
4ac囊中的“4”同样是扩张期囊胚,具备基本的移植条件。而“a”表示内细胞团细胞数量多、排列紧密,但“c”表示滋养层细胞稀疏。这类胚胎整体质量介于中等水平,优于4cc,但低于4aa、4ab等优质囊胚。
其实4bc和4ac囊胚的等级是相同的,也都不是最差的囊胚,这个囊胚的含义主要是根据囊胚的扩张状态、内细胞团和滋养细胞的发育进行评估,而从囊胚的几个等级评估来看,4bc和4ac囊胚属于一般的囊胚,并不是最差的囊胚,4cc才是最差的囊胚。
4bc和4ac移植成功率分别是多高
4bc和4ac囊胚的移植成功率受多种因素影响,一般来说,4bc囊胚属于中等级别,虽非优质胚胎,但已达到移植标准,所以移植的成功率大概在20%-40%左右。其成功率受女性年龄、子宫内膜环境、生活习惯等因素影响。

而4ac囊胚的内细胞团质量(a级)优于4bc囊胚(b级),但滋养层细胞质量(c级)与4bc相同。理论上,4ac囊胚的成功率可能略高于4bc,大致在30%-50%,但具体仍需结合个体情况判断。





